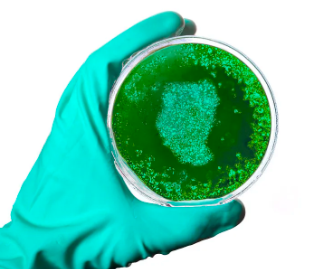
Dufeq™ Korean Avocado Exfoliating Scrub

Package Includes: 1 x Dufeq™ Korean Avocado Exfoliating Scrub
Dufeq™ Korean Avocado Exfoliating Scrub
$19.95 – $89.95
Nowadays, more and more people are using products for tanning and skin improvement. Everyone is gradually paying more attention to the side effects of these products. Many individuals experience skin sensitivity and enlarged pores after using skincare products. This Korean Avocado Scrub can help address these concerns. It is enriched with various plant proteins, made entirely from natural ingredients.
Blue algae extract, a treasure of vitality from the microalgae world, is rich in natural nutrients such as antioxidants, amino acids, and vitamin C, providing your skin with a continuous surge of energy to combat environmental stressors.Avocado plant oil, a gift from Mother Nature, boasts abundant vitamin E and fatty acids, offering your skin tender and moisturizing care. Its unique formula penetrates deep into your skin, nourishing dry and tired complexions, leaving your skin radiant and glowing.The perfect blend of these two natural wonders makes our product your skin’s secret weapon. Revel in its gentle exfoliating power, removing dead skin cells and unveiling a fresh new beginning. With no worries of side effects, our carefully crafted formula ensures you enjoy healthy, bright, and smooth skin.

DUFEQ Avocado Scrub also contains the following ingredients.
Natural vitamin C can help reduce free radical damage, promote collagen production, brighten the complexion, and improve uneven skin tone.

Avocado oil is rich in vitamin E and fatty acids, providing moisturizing and nourishing effects for the skin. It can also contribute to skin repair and protection.
Grape seed oil is a lightweight, easily absorbed plant oil, abundant in antioxidants and fatty acids, helping to maintain soft and moisturized skin.



Dr. Charlotte Meadon has been researching dermatology for 25 years. Let’s hear her perspective.
As a dermatologist, my evaluation of this exfoliating scrub is as follows:
DUFEQ Avocado Scrub is an impressive product. Its unique combination of ingredients, including avocado oil, clove leaf oil, eucalyptus oil, grape seed oil, and deep-sea plant stem cells, stands out for their high quality and efficacy.Avocado oil, rich in vitamin E and fatty acids, provides excellent moisturization and nourishment to the skin, aiding in repair and protection. Clove leaf oil and eucalyptus oil’s antibacterial and anti-inflammatory properties may improve skin conditions prone to acne. Grape seed oil, being a lightweight and easily absorbed plant oil, is abundant in antioxidants and fatty acids, contributing to soft and moisturized skin.Moreover, the inclusion of deep-sea plant stem cells is a notable feature. These plants grow in extreme environments and contain unique nutrients and antioxidants, promoting skin health and enhancing radiance.Additionally, the presence of vitamin C and sea salt adds to the appeal of this exfoliating scrub. Vitamin C, a potent antioxidant, helps reduce free radical damage, stimulate collagen production, brighten the complexion, and improve uneven skin tone. Sea salt exfoliates dead skin cells from the surface, leaving the skin smoother and more refined.

















Reviews
There are no reviews yet.